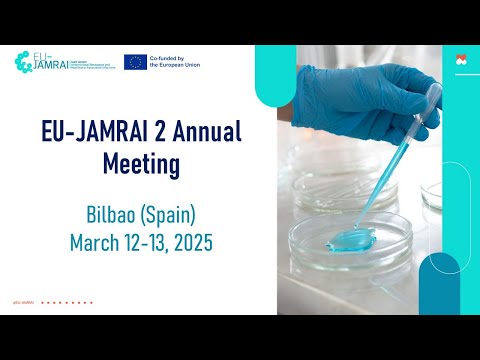
YouTube video

María Núñez retweetledi
María Núñez
425 posts

María Núñez retweetledi

🔝 La #UGR es Top100 mundial en Matemáticas, Ingeniería y Ciencias de la Computación, Inteligencia Artificial, Odontología, Educación y Turismo
📊 El @ShanghaiRanking de disciplinas mantiene el liderazgo de la Universidad de Granada
↘️ Toda la info
canal.ugr.es/noticia/global…
Español

@ssandofc @rocioasensi @FarmaciaHRUM @sefhcongreso @Farmacia_H_Pon @FarmaciaHCUVA @GEFP_SEFH @morilloverdugo @HUVMacarena @Epramel 🔝 @ssandofc gracias por compartir! Desde la @ugcfarmaciagr nos sumamos con las compis del Gregorio Marañón (Sara Ibáñez y Bea Torroba), la @CanalUGR y @athento al #RetoSEFH2030 #SEFH25 ▶️ Transformación digital aplicada a los #PROA 💜 y reto a @pnietog90 y @leoperianez

Español

@rocioasensi @FarmaciaHRUM @sefhcongreso @Farmacia_H_Pon @FarmaciaHCUVA @GEFP_SEFH @morilloverdugo Con el impulso de María Romero y la ayuda de muchos otros compañeros del @HUVMacarena . Gracias a todos. Esperando sea de utilidad y esperando siempre vuestro feedback.
Nos unimos con el reto ✅Integración asistencial
#RetoSEFH2030 y #sefh25
Y reto a @Epramel y @mamousseka

Español

Quedan 2 semanas para #sefh25 y ya puedes sumarte al #RetoSEFH2030 🌍🏥💡
Comparte en X o Instagram cómo contribuyes en tu día a día a alguno de los 20 retos y etiqueta a 2 compañeros para seguir impulsando esta iniciativa
Más info👇👇

Español
María Núñez retweetledi

🏅 La #UGR se posiciona como referente en #InteligenciaArtificial🤖, alcanzando el puesto 52 del mundo y 5 en Europa en el ranking Best Global Universities 2025 @USNewsEducation
📊 A nivel global ocupa el puesto 366 de un total de 2.551 instituciones
🔗 canal.ugr.es/noticia/ugr-pu…

Español
María Núñez retweetledi

🎉 ¡Celebramos 10 años de ciencia y salud!
📅 24 junio 📍@easpsalud
🔬 Jornada #XAniversarioibsGRANADA
🧠 Conferencias
🗣️ Mesas redondas
🎖️ Homenajes
🔗 ibsgranada.es/inscripcion-a-…
#InvestigaciónSanitaria #InnovaciónEnSalud #GranadaSalud @hospital_hvn @canalugr @clinicogranada

Español

A must-read! Excellent work @RetractionWatch @Profkkhan. Research integrity not only builds trust, it also saves lives!
Retraction Watch@RetractionWatch
Researchers emphasize need to "focus" on clinical trial integrity since they contribute "directly to healthcare practice and policy recommendations." frontiersin.org/journals/resea…
English
María Núñez retweetledi

#ESCMIDGlobal2025 Top 10 papers in ID: good to see BLING-III included @JAMA_current @UQHealth @UQ_News @CRE_RESPOND

English

@JGomezraja @EUjamrai @Fundesalud_Ex @saludEXT @Junta_Ex @AEMPSGOB @sanidadgob @CienciaGob @SaludISCIII @EU_Commission @EU_HaDEA Great team!
English
María Núñez retweetledi
María Núñez retweetledi
María Núñez retweetledi

Thank you to the experts from @Conecta13, @PRANgob, @AEMPSGOB, @clinicogranada, @EASPsalud, @ffarmaciaUGR, and @VeterinariosGRX for the valuable insights and contributions!




English
María Núñez retweetledi

EU-JAMRAI 2 Annual Meeting: 400 participants walking together to contain #AntimicrobialResistance
"Our EU-JAMRAI 2 identity is about building a One Health world together to reduce antimicrobial resistance. We have built a true One Health community in AMR"

English
María Núñez retweetledi

🤝 Una sola salud, un solo objetivo: Europa se une para preservar la eficacia de los antibióticos y proteger la salud humana, animal y ambiental
👏 Cerca de 400 participantes se han reunido en Bilbao en el encuentro anual de la acción conjunta @EUjamrai 2
aemps.gob.es/informa/una-so…
Español
María Núñez retweetledi

▶️ YouTube para divulgar la experimentación científica🧪
@Profkkhan, profesor de la #UGR, explica asuntos como la participación de los pacientes en las investigaciones y la ética de los estudios en su canal de @YouTube
Conoce más⬇️
canal.ugr.es/noticia/canal-…

Español
María Núñez retweetledi

The EU-JAMRAI 2 Annual Meeting goes on!
Join us and follow live today's session at this link👇 youtube.com/live/5fm2X97gU…
YouTube
English
María Núñez retweetledi

Continuamos con las sesiones de formación continua a referentes de #SeguridadDelPaciente de Andalucía.
Hoy Ángel Cobos Vargas, referente de #SegPac del @clinicogranada , nos comparte estrategias para implementar un programa de atención a segundas víctimas en centros sanitarios.


Español
María Núñez retweetledi
María Núñez retweetledi

PUBLISHED: The 2023-24 English surveillance programme for antimicrobial utilisation and resistance (ESPAUR) report gov.uk/government/pub…
Register to find out more about the findings in the report at the webinar we are hosting on 20th November: antibioticguardian.com/Meetings/espau…




English
María Núñez retweetledi

Welcome to World AMR Awareness Week & #EAAD 2024
Aim: to increase awareness of global antimicrobial resistance & to encourage best practice.
Tools, themes & signpost to key resources are available via the toolkit
gov.uk/government/pub…
#AntibioticGuardian #WAAW2024

English
María Núñez retweetledi

Compañeros del servicio de farmacia hospitalaria de @ugcfarmaciagr y @farma_gregorio participan en un proyecto de investigación, con financiación europea, para diseñar y pilotar una herramienta digital que evaluará el uso y la resistencia de antibióticos consalud.es/industria/herr…
Español










